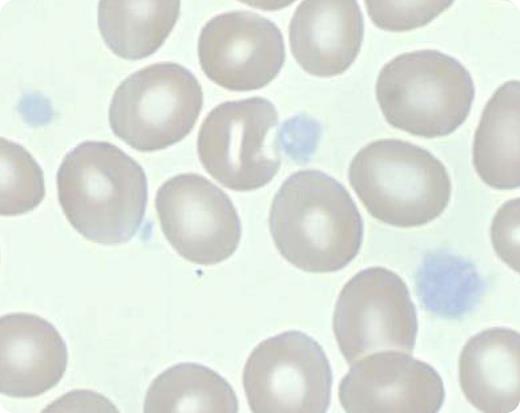
A 5-year-old girl was treated for 4 years based on a diagnosis of immune thrombocytopenia (ITP). When she presented for a second opinion, she met all criteria for ITP except that inspection of her peripheral blood smear showed large platelets with a complete lack of granulation, indicating a diagnosis of gray platelet syndrome (GPS). Electron microscopy subsequently showed absence of α-granules. / The name GPS comes from the gray appearance of the platelets in the peripheral blood smear as a result of the absence of α-granules. The genetic basis of GPS was recently demonstrated to be due to mutations in NBEAL2. The NBEAL2 gene encodes for the neurobeachin-like 2 (NBEAL2) protein, which is a member of the family of BEACH (BEige And Chediak-Higashi) domain-containing proteins on chromosome 3 (3p21). The NBEAL2 protein is likely involved in vesicular trafficking and may be critical for the development of α-granules. Patients with GPS have a life-long predisposition to mucocutaneous bleeding and are also predisposed to develop myelofibrosis. This case illustrates the importance of inspection of the blood smear before making a diagnosis of ITP.

A 5-year-old girl was treated for 4 years based on a diagnosis of immune thrombocytopenia (ITP). When she presented for a second opinion, she met all criteria for ITP except that inspection of her peripheral blood smear showed large platelets with a complete lack of granulation, indicating a diagnosis of gray platelet syndrome (GPS). Electron microscopy subsequently showed absence of α-granules.
The name GPS comes from the gray appearance of the platelets in the peripheral blood smear as a result of the absence of α-granules. The genetic basis of GPS was recently demonstrated to be due to mutations in NBEAL2. The NBEAL2 gene encodes for the neurobeachin-like 2 (NBEAL2) protein, which is a member of the family of BEACH (BEige And Chediak-Higashi) domain-containing proteins on chromosome 3 (3p21). The NBEAL2 protein is likely involved in vesicular trafficking and may be critical for the development of α-granules. Patients with GPS have a life-long predisposition to mucocutaneous bleeding and are also predisposed to develop myelofibrosis. This case illustrates the importance of inspection of the blood smear before making a diagnosis of ITP.
A 5-year-old girl was treated for 4 years based on a diagnosis of immune thrombocytopenia (ITP). When she presented for a second opinion, she met all criteria for ITP except that inspection of her peripheral blood smear showed large platelets with a complete lack of granulation, indicating a diagnosis of gray platelet syndrome (GPS). Electron microscopy subsequently showed absence of α-granules.
The name GPS comes from the gray appearance of the platelets in the peripheral blood smear as a result of the absence of α-granules. The genetic basis of GPS was recently demonstrated to be due to mutations in NBEAL2. The NBEAL2 gene encodes for the neurobeachin-like 2 (NBEAL2) protein, which is a member of the family of BEACH (BEige And Chediak-Higashi) domain-containing proteins on chromosome 3 (3p21). The NBEAL2 protein is likely involved in vesicular trafficking and may be critical for the development of α-granules. Patients with GPS have a life-long predisposition to mucocutaneous bleeding and are also predisposed to develop myelofibrosis. This case illustrates the importance of inspection of the blood smear before making a diagnosis of ITP.
For additional images, visit the ASH IMAGE BANK, a reference and teaching tool that iscontinually updated with new atlas and case study images. For more information visit http://imagebank.hematology.org.